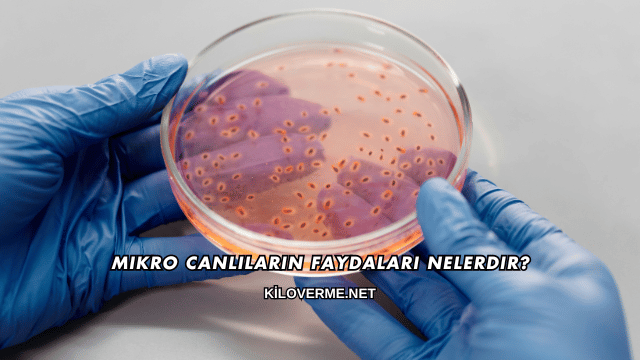
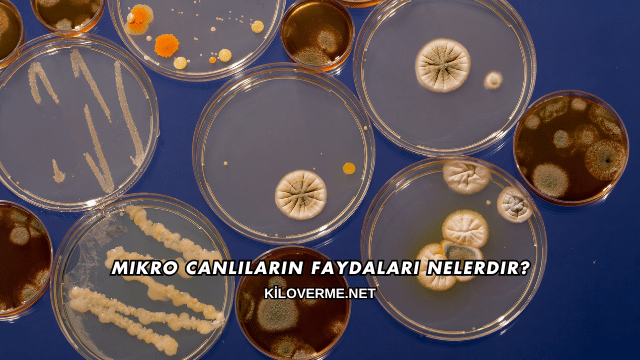

Mikro canlıların faydaları nelerdir sorusu son yıllarda hem bilim dünyasında hem de sağlık alanında en çok merak edilen konular arasında yer almaktadır. Gözle görülmeyecek kadar küçük olmalarına rağmen mikro canlılar, doğada dengeyi sağlamaktan insan sağlığını korumaya kadar pek çok alanda önemli işlevlere sahiptir. Probiyotiklerden toprak mikroorganizmalarına, deniz canlılarından endüstriyel kullanım alanlarına kadar geniş bir yelpazede insan yaşamına doğrudan ve dolaylı katkı sağlayan bu mikro varlıklar, bağışıklığı güçlendirmeleri, sindirimi kolaylaştırmaları ve çevresel döngülere katılımlarıyla yaşamın vazgeçilmez parçaları arasında gösterilmektedir.
Mikro Canlıların İnsan Sağlığına Katkıları Nelerdir?
Mikro canlıların faydaları nelerdir sorusuna verilen en önemli yanıtlardan biri insan sağlığı üzerindeki etkileridir. Sindirim sisteminde görev alan yararlı bakteriler besinlerin parçalanmasına yardımcı olurken probiyotikler bağışıklığı güçlendirir ve vücudu hastalıklara karşı korur. Ayrıca cilt ve ağız sağlığının korunmasında da rol oynayan mikro canlılar düzenli dengede olduklarında pek çok hastalığın önlenmesine destek olmaktadır.
Probiyotiklerin Vücuda Etkisi
Probiyotik mikroorganizmalar bağırsak florasının düzenlenmesinde büyük rol oynar ve bağışıklık sistemini güçlendirerek enfeksiyonlara karşı koruma sağlar.
Hangi Gıdalarda Bulunur?
Probiyotikler yoğurt, kefir, turşu ve benzeri fermente gıdalarda yoğun olarak bulunur ve düzenli tüketildiğinde vücut sağlığına katkıda bulunur.
Sindirim Sistemine Faydaları
Mikro canlılar besinlerin parçalanmasını kolaylaştırır, vitamin sentezini destekler ve sindirim sisteminin düzenli çalışmasına yardımcı olur.
Kabızlığa İyi Gelir mi?
Bağırsak hareketlerini düzenleyen yararlı mikroorganizmalar kabızlığın giderilmesinde etkili olur ve sindirim sürecini rahatlatır.
Mikro Canlıların Çevreye Katkıları Nelerdir?
Mikro canlıların faydaları nelerdir denildiğinde yalnızca insan sağlığı değil, çevresel katkıları da dikkat çeker. Toprakta yaşayan mikroorganizmalar organik atıkları parçalayarak doğanın döngüsünü sağlar ve bitkilerin büyümesine destek olur. Ayrıca su ekosistemlerinde görev alarak çevrenin temiz kalmasına yardımcı olurlar.
Toprak Verimliliğine Etkisi
Mikroorganizmalar toprağın mineral dengesini düzenleyerek bitkilerin daha hızlı ve sağlıklı büyümesine katkıda bulunur.
Tarımda Kullanılır mı?
Organik tarımda mikro canlılardan yararlanılarak hem toprağın yapısı korunur hem de ürün kalitesi artırılır.
Su Kaynaklarındaki Görevleri
Mikro canlılar su ekosistemlerinde atıkları parçalayarak doğal filtrasyon sağlar ve suyun temiz kalmasına yardımcı olur.
Deniz Canlılarını Korur mu?
Su ekosistemindeki mikroorganizmalar oksijen döngüsünü düzenleyerek balıklar ve diğer deniz canlılarının yaşamını destekler.
Mikro Canlıların Endüstride Kullanımı
Mikro canlıların faydaları nelerdir sorusuna bir başka yanıt da endüstriyel kullanım alanlarında görülür. Gıda üretiminden ilaç sektörüne, biyoteknolojiden enerjiye kadar pek çok alanda mikroorganizmaların varlığı önemlidir.
Gıda Üretiminde Kullanımı
Mikroorganizmalar yoğurt, peynir, ekmek ve turşu gibi birçok gıdanın üretiminde doğal fermantasyon sürecinde görev alır.
Alkol Üretiminde Rolü
Bira ve şarap gibi içeceklerin üretiminde maya mantarları alkol fermantasyonunu gerçekleştirerek içeceğe karakteristik özellik kazandırır.
İlaç Sanayisinde Katkıları
Mikro canlılardan elde edilen antibiyotikler ve vitaminler modern tıpta hayati öneme sahiptir ve birçok hastalığın tedavisinde kullanılır.
Aşı Üretiminde Kullanılır mı?
Mikroorganizmalar laboratuvar ortamında çoğaltılarak aşı üretiminde kullanılır ve bağışıklık sisteminin hastalıklara karşı korunmasına yardımcı olur.
Mikro Canlıların Ekonomiye Katkıları Nelerdir?
Mikro canlıların sağladığı ekonomik katkılar da oldukça büyüktür. Tarımdan gıda sektörüne, biyoteknolojiden ilaç sanayisine kadar geniş bir kullanım alanı sunan bu varlıklar ülkelerin ekonomik büyümesine doğrudan etki eder.
Enerji Üretiminde Rolü
Bazı mikroorganizmalar biyogaz üretiminde kullanılarak yenilenebilir enerji kaynağı olarak değerlendirilmektedir.
Yakıt Olarak Kullanılır mı?
Metan üreten bakteriler biyoyakıt elde edilmesinde görev alır ve fosil yakıtlara alternatif çevre dostu enerji sağlar.
Sanayiye Katkıları
Mikro canlılar endüstride hammadde üretimi, temizlik ürünleri geliştirme ve biyoteknolojik araştırmalar için de önemli bir kaynaktır.
Geri Dönüşümde Etkisi
Organik atıkların parçalanmasında görev alan mikroorganizmalar geri dönüşüm süreçlerini hızlandırarak çevre dostu çözümler sunar.

Mikro Canlıların İnsan Yaşamındaki Önemi
Mikro canlıların faydaları nelerdir denildiğinde hem sağlık, hem çevre, hem de ekonomi açısından sunduğu katkılar öne çıkar. İnsan yaşamının sürdürülebilirliği için mikroorganizmaların dengede kalması oldukça önemlidir.
Günlük Yaşamda Önemi
Mikro canlılar günlük hayatta tüketilen gıdalardan kullanılan ilaçlara kadar hayatın her alanında varlık gösterir.
Eksiklikleri Ne Gibi Sorunlar Yaratır?
Bağırsak florasında mikro canlı eksikliği sindirim sorunlarına, bağışıklık zayıflığına ve hastalıklara yatkınlığa neden olabilir.
Sıkça Sorulan Sorular
Aşağıda “Mikro Canlıların Faydaları Nelerdir?” ile ilgili sıkça sorulan sorular ve yanıtları yer almaktadır:
Mikro canlılar bağışıklık sistemini güçlendirir mi?
Probiyotik mikroorganizmalar bağırsak florasını dengeleyerek bağışıklığı güçlendirir ve vücudu enfeksiyonlara karşı korur.
Mikro canlılar kansere karşı korur mu?
Bazı mikroorganizmalar toksinleri azaltarak hücreleri serbest radikal hasarına karşı koruyabilir ve kansere karşı dolaylı fayda sağlayabilir.
Mikro canlılar tarımda neden önemlidir?
Toprağın mineral yapısını zenginleştirerek bitkilerin daha sağlıklı büyümesini sağlar ve ürün verimliliğini artırır.
Mikro canlılar suyu temizler mi?
Su ekosistemlerinde organik atıkları parçalayarak doğal bir filtreleme yapar ve suyun temiz kalmasına katkı sağlar.
Mikro canlılar enerji üretiminde kullanılır mı?
Metan üreten bakteriler biyogaz üretiminde görev alarak yenilenebilir enerji kaynağı oluşturur.
Mikro canlılar günlük hayatta nerelerde kullanılır?
Gıda üretiminden ilaç yapımına, aşı üretiminden biyoteknolojiye kadar birçok alanda aktif şekilde kullanılmaktadır.